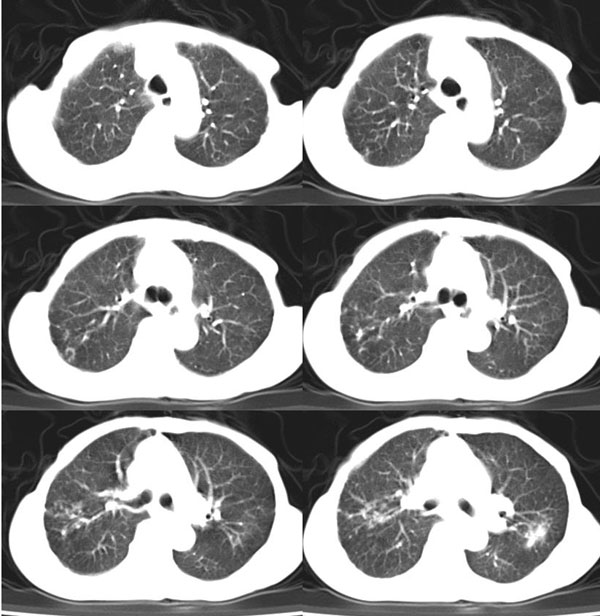

医影在线
标题: CT5199:[原创]胸部 强化+局部5毫米薄扫!请讨论!今天病例少 [打印本页]
作者: guzhongliangddd 时间: 2006-11-9 06:52
标题: CT5199:[原创]胸部 强化+局部5毫米薄扫!请讨论!今天病例少
女:73岁;因一月前感冒后咳嗽,发烧,有大量脓痰,并且有恶臭味。
5毫米局部薄平扫



局部5毫米强化



肺窗

图像有点请多慢慢看!
[本贴已被 翁志蓬 于 2006-11-9 0:26:34 修改过]
作者: 齐原 时间: 2006-11-9 06:59
右肺下叶肺脓肿
作者: 齐原 时间: 2006-11-9 07:03
补充_____伴双肺血行播散
作者: ssmmxx 时间: 2006-11-9 07:03
支持右肺下叶肺脓肿
作者: 守望可可 时间: 2006-11-9 07:09
标题: 回复
谢谢辜兄为我们网站的兴旺所做出的杰出贡献!右下肺脓肿并双肺感染、右胸膜粘连。[emb21][emb20]
[本贴已被 守望可可西里 于 2006-11-8 23:11:23 修改过]
作者: 医博云天 时间: 2006-11-9 07:31
肺脓肿,伴有支扩
作者: wangzhanshuang 时间: 2006-11-9 07:40
支持右肺下叶肺脓肿
作者: 奕帆 时间: 2006-11-9 07:56
肺脓肿,伴有支扩。
支持 !
别忘了治疗后复查!
作者: shenhs 时间: 2006-11-9 08:11
右下肺脓肿并双肺感染、右胸膜粘连。
作者: 眼睛 时间: 2006-11-9 08:49
影像加临床支持肺脓肿并双肺感染
作者: 卜一 时间: 2006-11-9 13:57
支持右肺下叶肺脓肿.
作者: 宝天曼 时间: 2006-11-9 14:55
支持右肺下叶肺脓肿
作者: 郭凯 时间: 2006-11-9 15:49
右下肺脓肿并双肺感染.
作者: sdw662 时间: 2006-11-9 16:14
支持右肺下叶肺脓肿.
作者: 1983 时间: 2006-11-9 17:04
右下肺脓肿并双肺感染
作者: dyqct 时间: 2006-11-9 17:22
考虑:1、右下肺脓肿;
2、支气管扩张合并感染。
作者: sun123456 时间: 2006-11-9 18:22
右肺下叶示片状致密影密度不均,内见一空洞有宽液平,并可见壁结节周围示散在斑片模糊影,左下肺亦见一斑片模糊影,考虑 肺脓疡,肺癌不除外。
作者: haha215315 时间: 2006-11-9 18:26
右下肺脓肿并双肺感染、右胸膜粘连。
作者: zyx168 时间: 2006-11-9 18:58
意见:1,右下肺脓肿;
2,双下叶支气管扩张;
3,慢支并感染,肺气肿,肺心病;
4,肺间质纤维化.
作者: yang4132 时间: 2006-11-9 19:13
右下肺脓肿,两下叶,中叶支扩并感染,右侧胸膜肥厚粘连。
作者: hhcckk 时间: 2006-11-9 19:29
发烧,有大量脓痰,并且有恶臭味,空洞,大液平,比较典型的肺脓疡
作者: elity69 时间: 2006-11-9 20:38
谢谢辜兄为我们网站的兴旺所做出的杰出贡献!右下肺脓肿并双肺感染、支扩,右胸膜粘连。
作者: kbzyycm 时间: 2006-11-9 21:13
支持右肺下叶肺脓肿
作者: jinguoji 时间: 2006-11-9 22:27
支持右肺下叶肺脓肿并双肺感染、右胸膜粘连。
作者: wnlyq8688 时间: 2006-11-10 00:36
肺脓肿并双肺感染
作者: guzhongliangddd 时间: 2006-11-10 01:32
该患者是我上个月作的,经正规抗炎治疗半月后平片显示吸收。{患者不愿ct复查}
作者: 拾荒者 时间: 2006-11-10 02:38
发烧,有大量脓痰,并且有恶臭味,空洞,大液平,比较典型的肺脓疡。谢谢楼主。
作者: xclzq_910 时间: 2006-11-10 04:07
1、右肺下叶肺脓肿
2、慢支伴感染
作者: shibing 时间: 2015-6-29 08:44
右下肺脓肿并双肺感染、右胸膜粘连。
| 欢迎光临 医影在线 (http://bbs.radida.com/bbs/) |
Powered by Discuz! X3.2 |